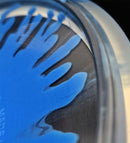
Fuse Opto-Ice Splash

Lagersaldo
| Color | Weight | I lager | Köp | Lägg till |
|---|---|---|---|---|
Pink
|
177+
|
3
|
White
|
177+
|
2
|
Pay with
Your payment information is processed securely. We do not store credit card details nor have access to your credit card information.
Description
Speed: 5.0
Glide: 6.0
Turn: -1.0
Fade: 0.0